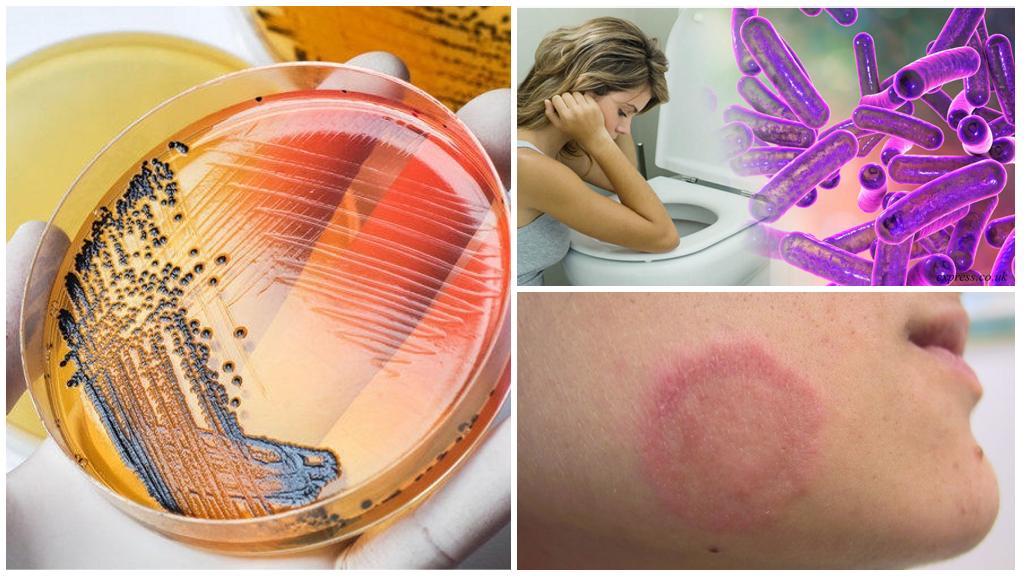

Блохи и дети
Риск развития серьезного недуга у детей увеличивается, когда ребенок не прошел вакцинацию.
Кожа у малышей нежная и болезненнее реагирует на укус паразита. Нередко возникают симптомы аллергической реакции. Она выражается в сыпи, мигренях, отечности мягких тканей. Паразиты гельминта не являются редкостью после укусов. При пальпаторном исследовании устанавливается увеличение лимфатических узлов. В группе риска дети, чьи родители позволяют кошке или собаке спать в кровати.
Родителям обязательно следует знать, какие болезни переносят блохи. Это позволит своевременно выявить заражение и обратиться к врачу. Своевременное лечение снизит риск развития осложнений, таких как аллергия, отеки.
После укусов насекомых у детей отмечаются глисты, снижение иммунитета, признаки язвенного поражения.
Паразиты представляют опасность и для беременных женщин. В данный период, заражение приводит к аллергии, в результате чего нарушается процесс формирования и развития плода.
Размножение
Тараканы принадлежат к насекомым с неполным метаморфозом (превращением). У них отсутствует стадия куколки, а личинки принимают вид взрослой особи путём нескольких линек.
Размножаются рыжие прусаки на протяжении всего года.
Самочки откладывают яйца (около 30 штук) в небольшую капсулку коричневого цвета (оотеку). Будущее потомство женская особь носит с собой на конце брюшка (выступающую часть оотеки видно невооружённым глазом) вплоть до вылупления личинок (2-4-недели).
Первоначальный цвет личинок — белый, постепенно он темнеет. Личинки (нимфы) претерпевают шесть линек, пока не принимают вид имаго. За всю жизнь самки вынашивают от четырёх до десяти оотек и способствуют появлению на свет до 300 молодых тараканов.
Сколько живут рыжие тараканы?
Продолжительность жизни рыжих прусаков в домашних условиях и при достаточном количестве пищи и воды составляет от 8 до 10 месяцев (этот отрезок времени включает продолжительность жизни имаго (7 — 8 месяцев) и стадию нимфы).
Образ жизни тараканов, вред для людей
Вред от тараканов для человека
Чем опасны тараканы для человека в квартире, описывают в каждой научной статье, но мало кто обращает внимание на эту информацию, пока не столкнется лицом к лицу с насекомыми в собственном доме. Тараканы ведут ночной образ жизни, предпочитают прятаться в сырых темных местах, селятся вблизи пищевых остатков
Многочисленными колониями поселяются в подвалах, заброшенных зданиях, подъездах, мусорных баках, канализации.
В поисках пищи не брезгуют никакими отходами, поедают гниющие овощи, фрукты, продукты жизнедеятельности человека, грызут трупы животных, в особенности мышей, крыс.
Опасны ли тараканы – ответ утвердительный. На своих лапках насекомые переносят целые колонии болезнетворных микроорганизмов, вирусов, бактерий. После жизни в канализации, мусорках прусаки лазят по столу, продуктам, оставляя после себя кишечную палочку, грибки, бактерии.
Тараканы как переносчики заболеваний человека
Главная опасность тараканов для человека непосредственно связана с тем, что эти насекомые могут легко перемещаться между помещением квартиры и любыми другими пространствами жилого дома, в том числе канализацией, мусоропроводом, подвалами и чердаками. В этих, прямо скажем, не очень чистых местах насекомые собирают на свои хитиновые покровы огромное количество самых разных бактерий: в подвалах они бегают там же, где кормятся крысы, на чердаках копошатся в птичьем помете, а в канализации контактируют с человеческими нечистотами.


Не удивительно, что на их телах (особенно на лапках и брюшке) оседают различные болезнетворные бактерии, а также споры грибков и яйца гельминтов (иначе говоря – глистов). А дальше тараканы переносят возбудителей болезней и прочее собранное «хозяйство» в жилое помещение: уже через несколько часов все это оказывается на вашем кухонном столе, в хлебнице, на неубранных в холодильник продуктах питания или даже в стакане, из которого вы пьете. И слава Богу, если это не окажется на детской соске.


Кроме того, регулярно питаясь отходами (и чего уж греха таить, даже экскрементами человека и животных в канализации, подвалах и чердаках), тараканы собирают в своей пищеварительной системе немалый спектр патогенных микроорганизмов. Специальные исследования показали, что обычные рыжие и черные тараканы способны переносить возбудителей следующих болезней:
См. также наши эксперименты на тараканах:
Мы ловим тараканов и тестируем на них разные средства – смотрите результаты…
Редкий по убойности эффект: тестируем аэрозоль Рейд на тараканах
Тестируем мелок Машенька на тараканах и смотрим, что из этого получилось
Посмотрим, эффективен ли обычный огородный Карбофос против тараканов
Испытываем действие аэрозоля Раптор на тараканах
Экспериментально проверяем, насколько быстро работает «Рейд против тараканов и муравьев»
Испытываем на тараканах действие порошка Фенаксин – эксперимент с неожиданным результатом…
- Статья: Где тараканы обычно прячутся в квартире и могут ли они ползти из канализации?
- Дизентерия;
- Гастроэнтерит;
- Ряд урогенитальных инфекций;
- Сальмонеллез;
- Менингит;
- Микобактериоз;
- Пневмония;
… и некоторых других.
На лапках тараканов, в их желудках и экскрементах могут присутствовать яйца опасных гельминтов:
- Аскарид;
- Остриц;
- Лентецов;
- Власоглава;
… а также цисты патогенных амеб.
Особенно велик вред от тараканов, попадающих в квартиру из канализации (некоторые их даже называют канализационными тараканами). Не известно, где и в чем несколько часов назад барахталось это насекомое, и какой набор гадостей оно оставит на хлебе, по которому пробежит.

Все вышеперечисленные микроорганизмы и яйца гельминтов попадают на продукты питания, а также на различные поверхности элементов интерьера на кухнях, в ванных комнатах и уборных. В дальнейшем заражение человека может произойти не только через продукты питания, но и просто по цепочке: грязная поверхность – немытые руки. В итоге, уже находясь в больнице, человек может даже и не подозревать, где именно он подцепил неприятную болезнь.
И еще: Тараканы попрятались по всем щелям и никак до них не добраться? А дымовые шашки достают их даже там, куда не протиснется иголка…
Люди нередко грешат на общественный транспорт, столовые или сомнительные продукты с рынка, а на самом деле иногда в таких случаях стоило бы посмотреть, как обстоят дела с тараканами в их собственной квартире…

Особенно опасны тараканы в школах и в детских садах, где они вполне могут стать виновниками массового распространения инфекций. Поэтому если в таком учреждении регулярно обнаруживаются насекомые, то имеет смысл срочно озаботиться их уничтожением. Если же сотрудники детского сада и школы не слишком расторопны в этом отношении, то всегда можно пообщаться с руководством – оно уж точно в курсе всей серьезности такой ситуации (в том числе и для них лично).
Какие болезни переносят тараканы
Согласитесь, никто не станет есть из тарелки, где был замечен таракан. И совершенно правильно ! Вот лишь несколько заболеваний, распространителем которых могут быть тараканы :
- Гастроэнтерит
- Менингит
- Дизентерия
- Пневмония
- Сальмонеллез
Потенциальную опасность несут не только продукты, по которым пробежал таракан. Патогенные микроорганизмы могут проникнуть в организм человека с поверхности мебели или предметов быта. Мойте руки как можно чаще! Подхватив заболевание, испытав расстройство желудка, люди ломают голову над причиной случившегося. Сетуют на общественный транспорт, антисанитарные условия в магазинах и столовых. А между тем истинный вредитель кроется в их собственном доме.
Почему тараканы выползают ночью, и чем они опасны для спящего человека
Тараканы – существа боязливые, и в светлое время суток стараются держаться в укрытиях: в щелях плинтусов, в выдвижных ящиках и петлях кухонной мебели, в полостях стен и других незаметных местах. При свете эти насекомые не чувствуют себя в безопасности, вот почему тараканы появляются ночью, когда в квартире тихо и темно. Когда люди ложатся спать, у них наступает время поиска необходимых для жизни пищи и воды.
Как уже упоминалось выше, ночью тараканы могут залезть в постель и даже ползать по человеку. В фазе глубокого сна люди не ощущают, как по ним бегают насекомые, и потому не защищены от того, чтобы тараканы забрались в приоткрытый рот, нос или ухо. Если эта ситуация кажется вам чересчур курьезной, то уверяю вас, что на практике подобные случаи далеко не единичны. А людям, которым ночью таракан залезал в ухо, поверьте, было совсем не до смеха – это глубокий стресс и серьезная угроза здоровью, вплоть до потери слуха.
Когда-то давно тараканы считались признаком небрежного ведения домашнего хозяйства и неряшливого образа жизни. Теперь чиновники от здравоохранения признают, что даже у щепетильных к чистоте домохозяек могут появиться тараканы, особенно если те живут в теплых климатических широтах, крупных городах или ветхих зданиях. Но как бы то ни было, ясно понимая, чем опасны тараканы в доме, не допускайте бесконтрольного размножения вредителей в своей квартире.
Какие болезни переносят тараканы
Разносчики инфекций, прежде чем проникнуть в квартиру, часть своей жизни проводят в сточных и канализационных трубах, подвалах, на чердаках. В этих местах встречаются трупы различных животных, мусор. В результате на хитиновых оболочках вредителей оказываются: грибки, болезнетворные микробы, яйца гельминтов и другие вредные и опасные микробы. В организм насекомых через пищу попадают экскременты животных, химия, отходы человеческой жизнедеятельности, содержащие патогенные микроорганизмы. Тараканы разносят их по дому, они попадают на продукты питания, одежду, мебель.
Болезни от тараканов Ученые проводили многочисленные исследования. По их результатам было выяснено, что на своем теле тараканы переносят болезни, которыми могут заразить людей. К ним относятся:
Болезни от тараканов Ученые проводили многочисленные исследования. По их результатам было выяснено, что на своем теле тараканы переносят болезни, которыми могут заразить людей. К ним относятся:
- лишай;
- дифтерия;
- полиомиелит;
- проказа;
- сальмонеллез;
- дизентерия;
- столбняк и другие болезни, опасные для человека.
Эти инфекции во время исследований были обнаружены в организме рыжих и черных особей, обитающих в квартирах, учебных и дошкольных учреждениях
Что делать, если был контакт с больным человеком
Инкубационный период ротавируса может значительно варьироваться и составлять от нескольких часов до недели. Это зависит от иммунитета человека и наличия некоторых хронических заболеваний. Из-за такого инкубационного периода человек еще не знает, что он болеет, и продолжает контактировать с широким кругом людей. Если человек узнал, что кто-то из его круга общения заболел такой инфекцией, он начинает переживать и думать, что же делать.
Для профилактики ротавирусных инфекций у взрослых после непосредственного контакта с больными можно принимать противовирусные препараты – «Гропринозин», «Изопринозин» или «Арбидол». В большинстве случаев эта мера позволяет избежать кишечной инфекции.
Хорошей профилактической мерой являются прививки от ротавируса. Их делают несколько раз, и этого хватает, чтобы защитить себя или ребенка от болезни на пару лет.
Если заболела кормящая мама
Если ротавирусом заразилась кормящая женщина, то, чтобы не заразить грудного ребенка ротавирусом, нужно соблюдать ряд правил:
- Отказаться от кормления ребенка грудью на весь период болезни. Можно временно перевести грудничка на молочные смеси или сцеживать молоко, а затем его кипятить.
- По возможности на время отойти от ухода за малышом. Если такой возможности нет, то женщина надевает марлевую маску и тщательно моет руки, перед тем как взять кроху.
- Туалет, ванная и кухня часто моются.
- В комнате, где находится ребенок, регулярно протирают все поверхности и помещение проветривают.
По возможности заболевшую маму изолируют в отдельной комнате, а уход за ребенком возлагают на папу и бабушек. Такой подход поможет не заразить маленького ребенка ротавирусом.
Аллергия на тараканов
Не менее значительный вред тараканы могут наносить человеку как источники аллергенов в квартире. Большое количество хитиновых покровов, остающихся после линьки насекомых, сухие экскременты, останки умерших особей – все это смешивается с домашней пылью, и при попадании на кожу, в пищеварительный тракт или в дыхательные пути человека иногда вызывает тяжелые заболевания:
- Аллергический ринит с сильным насморком и конъюнктивитом;
- Бронхиальную астму;
- Дерматит.

Важно то, что аллергия на тараканов часто бывает хронической: сталкиваясь с продуктами их жизнедеятельности каждый день в своем доме, человек постоянно контактирует с аллергеном, и симптомы заболевания у него не проходят вообще (нередко встречается и у детей). Выраженные симптомы аллергии на тараканов – это обычно чихание, резь в носу и в глазах, обилие прозрачной слизи, вытекающей из носа

Следует отметить, что черные тараканы имеют сильный неприятный запах. Когда этих насекомых в помещении немного, он не особенно заметен, но когда вредители размножаются в значительных количествах, квартира начинает характерно и неприятно пахнуть.

Избавиться от такого запаха тараканов можно единственным способом – уничтожить самих насекомых, после чего убрать их останки, экскременты и хитиновые покровы, оставшиеся после линьки (все это «добро» может годами копиться по углам квартиры, под плинтусами, за кухонной плитой, холодильником, за вентиляционной решеткой и в различных щелях).
Тараканы
Встретить этих шестиногих товарищей можно не только вне дома, но и в его пределах. Они долго могут обходиться без еды, способны повреждать целостность продуктов, кожаных изделий, книг. Тараканы всеядны и могут питаться отбросами или фекалиями. Многие из них передвигаются по канализации, мусоропроводу или чердаку. Поэтому их образ жизни может негативно отразиться на любом человеке: угрожать гастроэнтеритом, дизентерией или диареей.
Отдельные виды тараканообразных, например, желтые тараканы, могут укусить (в область шеи, сгибы конечностей). В результате появляется ранка с небольшой корочкой, которая может воспалиться. На лапках и брюшке тараканы переносят множество патогенных микроорганизмов. При расчесывании волдыря они способны попадать внутрь и паразитировать в организме человека. Укусы тараканов обязательно необходимо обрабатывать антисептиком.
Запишитесь на прием к дерматологу в сеть медицинских центров “ОН Клиник” вашего города, если вас укусило насекомое. Опытный врач поможет эффективно и быстро справиться с последствиями любого укуса.
Наслаждайтесь летом, но будьте внимательны и осторожны!
Рейтинг статьи:
5 из 5 на основе 3 оценки
Аллергия на тараканов
Тараканы опасны для человека еще и тем, что провоцируют аллергическую реакцию. К основным компонентам, из-за которых возникает аллергия на тараканов, относят:
- Сбрасываемый хитиновый покров.
- Экскременты.
- Органические остатки.
- Умершие и высохшие особи.
Если заражение квартиры вредителями сильное, то и объем аллергенов огромен. Они смешиваются с пылью, после чего попадают в дыхательные пути или оседают на кожном покрове.
Чтобы оценить, опасны ли останки тараканов, необходимо определить частоту контакта. Если контакт единичен, то здоровью людей это не навредит. При постоянном контакте возрастает вероятность возникновения таких заболеваний:
- Ринит аллергический. Он сопровождается сильным насморком. Иногда возникает и конъюнктивит.
- Дерматит.
- Бронхиальная астма.
У детей аллергия на тараканов нередко перерастает в хроническую форму. Это бывает из-за того, что ребенок постоянно контактирует с присутствующими в доме аллергенами. Поэтому симптомы аллергии на тараканов не проходят. Состояние некоторых людей ухудшается.
Основная симптоматика аллергии на вредителей:
- Выделение слизи из глаз и носа.
- Чихание.
- Покраснение и раздражение.
Если аллергический ринит переходит в хроническую форму, в носу формируются и развиваются полипы. Со временем ухудшается дыхание. Некоторые пациенты, у которых аллергия на тараканов, возникает астма.
Посмотрите интересное видео какие заболевания переносят тараканы.
Более неприятным запахом отличаются черные вредители. Если их численность небольшая, то запах практически незаметен. При увеличении популяции в воздух попадают аллергенные компоненты. Воздух в доме насыщается неприятными ароматами.
Чтобы ликвидировать неприятный запах, необходимо провести обработку всех жилых и подсобных помещений. Для обработки подходят:
- Гели и пасты.
- Аэрозоли и спреи.
- Мелки.
- Порошки.
Домохозяйки пользуются и народными средствами. Среди популярных народных средств выделяют:
- Приманки.
- Ловушки.
- Уксус и скипидар.
- Герань, полынь.
Как только насекомые ликвидированы, хитиновые покровы и останки убираются. Отыскать остатки несложно, поскольку они располагаются под плинтусами или за мебелью. Во время уборки проверяют состояние вентиляционных шахт и отверстий.
Болезни из-за прусаков
Тараканы опасны не только распространением инфекции, но и развитием болезней, не связанных с бактериями. Присутствие мерзких насекомых раздражает нервную систему, человек боится уснуть, развивается бессонница. Плохой сон ухудшает самочувствие, вызывает слабость, подрывает иммунитет. Организм становится открытым для проникновения вирусов, бактерий, грибов. Болезни передающиеся от тараканов
Болезни передающиеся от тараканов
У маленьких детей существует риск развития фобии, которая официально получила название блаттофобии. Другими словами, боязнь тараканов. Серьезное заболевание психики, которое заставляет уже взрослых людей вести себя неадекватно при виде маленького насекомого.
У больного блаттофобией во время приступа учащается пульс, повышается артериальное давление, краснеет либо бледнеет лицо, повышается потоотделение. Взрослый человек визжит, кричит, вскакивает на стул. Тараканы преследуют в кошмарном сне.
Чтобы вылечить серьезное заболевание, недостаточно приема медикаментов. Требуются длительные сеансы психотерапевта, работа над собой, перепрограммирование подсознания.
Переносчики опасных болезней
Рыжие и черные тараканы не относятся к паразитам. Они проникают в квартиры и дома, поскольку здесь благоприятные условия для развития и размножения.
Ученые отмечают, что сегодня известно более 4,5 тысяч видов. Но с медицинской точки зрения значимыми считаются те виды, которые потребляют продукты питания, органические остатки. Домашние тараканы, которые зачислены в группу риска, переносят на покрове и лапках не только грязь.
Переносимые тараканами инфекции различны:
- Болезнетворные микроорганизмы.
- Грибки.
- Простейших.
- Вирус полиомиелита.
- Гельминтов яйца.
Хотя вредители и являются переносчиками этих опасных болезней, но на их состояние патогенная микрофлора не влияет.
Если не использовать для борьбы народные или химические средства от тараканов, то последствия могут быть плачевными. Специалисты отмечают, что вредители заражали людей самыми опасными заболеваниями:
- Сальмонеллезом.
- Менингитом.
Понимая, чем опасны домашние тараканы в квартире, человек делает все возможное, дабы избавиться от них.
Какие болезни переносят
Блохи, живущие на животном и человеке, являются распространителями опасных заболеваний, многие из которых приводят к летальному исходу. Паразиты становятся источником заражения.
Насекомые становятся причиной развития сибирской язвы. Заболевание проявляется в виде поражения легких, кожного покрова, кишечника. Основными признаками являются язвы, повышенная температура, отечность мягких тканей.
Блохи являются переносчиками глистов. Они живут в органах ЖКТ, нарушая целостность слизистой. У пациентов повышается аппетит, возникает зуд в заднем проходе, боли в животе.
После укуса могут возникать признаки сыпного тифа, выражающиеся в повышении температуры, появлении сыпи. У больных наблюдаются признаки интоксикации. Насекомые способны стать причиной листериоза и грибковых инфекций.
Кровососущие переносят тиф, энцефалит, гепатит
Поэтому следует соблюдать меры предосторожности и своевременно обращаться к врачу.
Блохи переносят бешенство и лишай. Заболевания представляют опасность для человека и требуют незамедлительного лечения. В первом случае начальными симптомами являются повышение температуры, воспаление ранки после укуса, бессонница.
Лишай характеризуется появлением на кожном покрове покраснений. Очаг патологического процесса разрастается, сопровождается зудом, жжением.
Чем вредны тараканы в квартире и в доме?
То, что тараканы – переносчики болезней, слышали все. Но чем именно можно заболеть от этих насекомых, знает не каждый
На деле предотвращать заражение квартиры и прекращать жизнедеятельность насекомых путем их вытравливания очень важно. Они свободно перемещаются по любым поверхностям, залезают в самые маленькие щелки, ползают по мусоропроводу, мусорным бакам, подвалам и чердакам, откуда приносят в жилье человека разных микробов

Тараканы прогуливаются по мусоропроводу, собирая там болезнетворных микроорганизмов, а потом приходят к Вам в дом и повсюду оставляют эту заразу
Какие болезни переносят тараканы? Список внушителен:
- Менингококки
- Микобактерии
- Сальмонеллы
- Возбудители гастроэнтеритов
- Возбудители урогенитальных инфекций
- Синегнойная палочка
От неприятных соседей можно заразиться даже дизентерией, пневмонией, а также рядом гельминтозов. Тараканы вполне способны принести в жилье человека яйца аскарид и остриц, лентецов, власоглава. Конечно, людей насекомые побаиваются и близко к ним не подходят. Но во время поедания человеческой пищи или ползания по посуде они оставляют на ней слюну и отходы жизнедеятельности с микробами, поэтому заполучить ряд инфекций человек все-таки может.
Белый таракан в квартире – Лучшие средства для уничтожения

Домашние тараканы способны разносить и вирусные болезни. Самые тяжелые из них – гепатит и туберкулез, не говоря уже о разных типах энтеровирусов. Таким образом, насекомые реально опасны для человека и его здоровья. Усугубляет ситуацию то, что в подвалах, канализациях и мусоропроводах обитают крысы, которые переносят еще более серьезные болезни, а на чердаках живут голуби, порой считающиеся еще опаснее крыс. Вся зараза, разносимая этими животными, вполне может достаться и домашнему таракану.
Это нужно знать: 3 главных болезни от тараканов:
https://youtube.com/watch?v=YlX2E5OANtU
Меры предосторожности в лечебных учреждениях
Если ротавирус протекает тяжело или ребенок слишком маленький, то больного помещают в больничный стационар. Чтобы предотвратить случаи заболевания среди остальных пациентов, соблюдают такие меры:
- Больных с ротавирусом помещают в отдельные боксы или полубоксы, но в последнем случае в обеих палатах должны находиться люди с одинаковым диагнозом.
- Ограничивают передвижение больных кишечной инфекцией по коридорам.
- Часто моют палаты дезинфицирующими средствами и кварцуют.
Чтобы не заболело большое количество людей в инфекционной больнице, пациентов в ротавирусом размещают в отдельном крыле. Если это условие не соблюдается и такие люди находятся в непосредственной близости от прочих больных, то это грозит вспышкой инфекции.
Тараканы и наносимый ими вред
Вред, наносимый домашними насекомыми, ученые называют блаттоптерозом:
- Тараканы переносят серьезные заболевания.
- Способны вызывать аллергию.
- Портят продукты питания.
- Кусаются, пусть даже не целенаправленно и почти неощутимо.
- Залезают в нос или в уши, что требует обязательного обращения за профессиональной помощью врача.
Вред для здоровья человека
Нечистоплотные насекомые собирают на свои хитиновые покровы бактерии и микробы. В поисках продуктов питания они проползают через канализации, мусоропроводы, чердаки и подвалы. До того как тараканы попадают на кухню, они кормятся в подвалах, копошатся в птичьем помете и контактируют с другими нечистотами.
Споры грибков и яйца гельминтов тараканы переносят на брюшке или лапках. Весь этот опасный для здоровья набор они несут на продукты, которые остаются на столе или в хлебнице. Тараканы являются переносчиками следующих заболеваний:

- гастроэнтерит;
- дизентерия;
- сальмонеллез;
- пневмония;
- менингит;
- микобактериоз;
- урогенитальные инфекции.
Неизвестно, в каких условиях ползал таракан, пока оказался в вашем доме. Он может оставлять микробы и бактерии не только на продуктах питания, но и на всех поверхностях в комнатах и на кухне. Прикасаясь к ним, можно подцепить одно из заболеваний, которые переносят тараканы. Чем больше насекомых в доме, тем больше опасность заразиться.
ВОсобенно чревато присутствие тараканов для маленьких детей. Оставленная без присмотра соска, по которой проползет таракан, может доставить немало неприятностей.
Мало кому известно, что тараканы способны вызывать аллергию, точнее, даже не сами насекомые, а останки линьки, сухие экскременты, пустые и высохшие оотеки. Смешиваясь с домашней пылью, они провоцируют аллергическую реакцию. Попадая на кожу, в дыхательные пути или пищеварительный тракт, они вызывают:

- бронхиальную астму;
- дерматит;
- аллергический ринит.
Часто человек не может понять, что именно вызвало такую реакцию организма, греша на пыль в доме. Но если есть черные или рыжие тараканы, то регулярные уборки не помогут. Аллергия на тараканов проявляется в виде:
- рези в носу и глазах;
- чихания;
- выделений в виде прозрачной слизи из носа.
Так, ночное насекомое иногда принимает человеческое ухо за отличное укромное убежище, из которого не спешит выселяться.
Доставать паразита самостоятельно небезопасно. Следует обязательно обратиться за медицинской помощью.
Насекомое может случайно оказаться даже в человеческом носу, провоцируя насморк и доставляя неприятные ощущения.
Тараканы кусаются

Но это происходит не так, как с другими насекомыми — комарами, клещами, клопами. Тараканы объедают частицы ороговевшей кожи, часто даже на лице. Но делают они это в редких случаях, сильно проголодавшись. Даже если вас покусал таракан, вы вполне могли этого даже не заметить во сне. Известны случаи, когда морякам во время плавания приходилось спать в перчатках, так как голодные тараканы объедали кожу на пальцах до такой степени, что на них появлялись видимые раны. Зависимые от воды насекомые могут «пить» слюну с губ спящего человека, если других источников влаги в доме нет.
Насекомые способны поломать оборудование и испортить изоляцию
Их ротовой аппарат устроен таким образом, что разрушить твердые материалы не составляет труда. Это особенно актуально, когда тараканов много и они голодны. Их активность приводит к поломкам и даже короткому замыканию.
Домашние вредители портят продукты питания
Преимущественно они ведут охоту на хлеб, фрукты, кондитерские изделия. Но если на пути таракана будет другой продукт, то он и его не проигнорирует. Если насекомое попало в холодильник, будьте уверены, что оно пробежалось по всем продуктам. Если вспомнить о том, где тараканьи лапки могли побывать до этого, то употреблять в пищу такие продукты опасно.
https://youtube.com/watch?v=eboTwGiQTw8
Общая информация и строение
Блохи относятся к разряду насекомых. Они отличаются небольшим размером. У насекомых отсутствуют крылья. Окрас от светлого до темного, зависит от разновидности паразита.
Насекомые живут и паразитируют на животных, питаясь кровью. Размер блох составляет не больше 0,5 см.
Вредители встречаются во всех странах и являются переносчиками болезней. Кровососущие способны выживать в экстремальных условиях. Раздавить паразита в результате морфологического строения тела затруднительно.
Насекомые не летают, они распространяются с помощью прыжков на большие расстояния. Заражению паразитами подвержены люди. Блохи человеку передаются от животных. Высота прыжка насекомого составляет 50 см.
В чем опасность
Насекомые, переносимые животными, кусают, оставляя на теле красные отметины. В результате возникает воспаление, зуд, жжение, что вызывает дискомфорт. С течением времени проявляются признаки заражения.
Вредители способны жить на здоровом и ослабленном организме. Во время укуса вместе со слюной в кровь попадает множество вирусов.
Заразиться от блох может любой человек. Распространенными заболеваниями, переносимыми паразитами являются туляремией, сибирской язвой, бруцеллезом, пастерелезом, псевдотуберкулезом. Это опасные заболевания, приводящие при отсутствии терапии к смертельному исходу.
Опасны животные с блохами, которые живут рядом с человеком, так как являются переносчиками насекомых. Кровососущие перепрыгивают на кожу человека, живут в волосяном покрове.
Дракункулез
Сегодня он встречается только в Африке. Дракункулез — болезнь собак, обезьян, людей и шакалов. Вызывают ее очень длинные («драконовы») круглые черви. Их личинки переносят рачки-циклопы, животные настолько мелкие, что человек может их проглотить вместе с пресной водой и даже не заметить. Черви, проникшие в организм человека, поселяются в подкожной клетчатке и вырастают там до длины 1-1,5м. Целый год заболевание протекает без симптомов. Потом черви-самки начинают прорываться на поверхность, чтобы отложить личинки, при этом человек ощущает слабость и головокружение, на коже появляются зудящие волдыри.
Как избежать?
Пить только кипяченую воду, не купаться в пресных водоемах.
Как проявляется хламидиоз у мужчин
У мужчин проявление хламидиоза сопоставимо с симптомами уретрита, и на первых стадиях многие не обращают на проблему внимания, полагая, что все вызвано воспалением после простуды или прочими «пустяковыми» факторами.
Хламидиоз у мужчин может давать следующие симптомы:
- Прозрачные слизистые выделения из мочеиспускательного канала.
- Наличие гноя в моче и ее помутнение.
- Изменяется цвет мочи, могут появиться кровянистые выделения, которые также могут присутствовать в семенной жидкости во время семяизвержения.
- Мочеиспускание сопровождается жжением или ощущением рези.
- Появляются спонтанные боли в области малого таза, поясницы, мошонки.
- Наблюдается субфебрильная температура (держится повышение от 37.1 до 38 град.).
- Общее физическое недомогание.
Бывает, что хламидии у мужчин образуют локальные колонии без общего заражения организма. Очаговые скопления без развития инфекционного заболевания, обусловлены сильным иммунитетом и сопротивляемость антител к воздействию хламидий. При этом мужчина остается заразным.






































